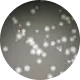

시스템에어컨 세척의 필요성
실내 공기질 개선과 에너지 효율을 위해
시스템에어컨 세척은 꼭 필요합니다.
전문적인 관리가 어려운 시스템에어컨 내부에는 인체에 유해한
곰팡이와 세균이 축적됩니다.
이로 인해 호흡기 질환이 발생 할 수 있으며 또한, 냉·난방 효율 저하의 원인이 될 수 있어 주기적인 세척 서비스가 필요합니다.
장기간 미세척한 제품 내부에서
각종 세균과 곰팡이균이 발생하게 된다면?

-

폐렴간균
-

리스테리아균
-

바실러스균
-

곰팡이균
-

대장균
-
레지오넬라균
-

황색포도상구균
-

살모넬라균
-
불쾌한 냄새가
발생할 수 있습니다. -
에어컨 내부 세균이
건강을 해칠 수 있습니다. -
냉·난방 효율이 저하되어
전기료가 증가될 수 있습니다.
















































































































